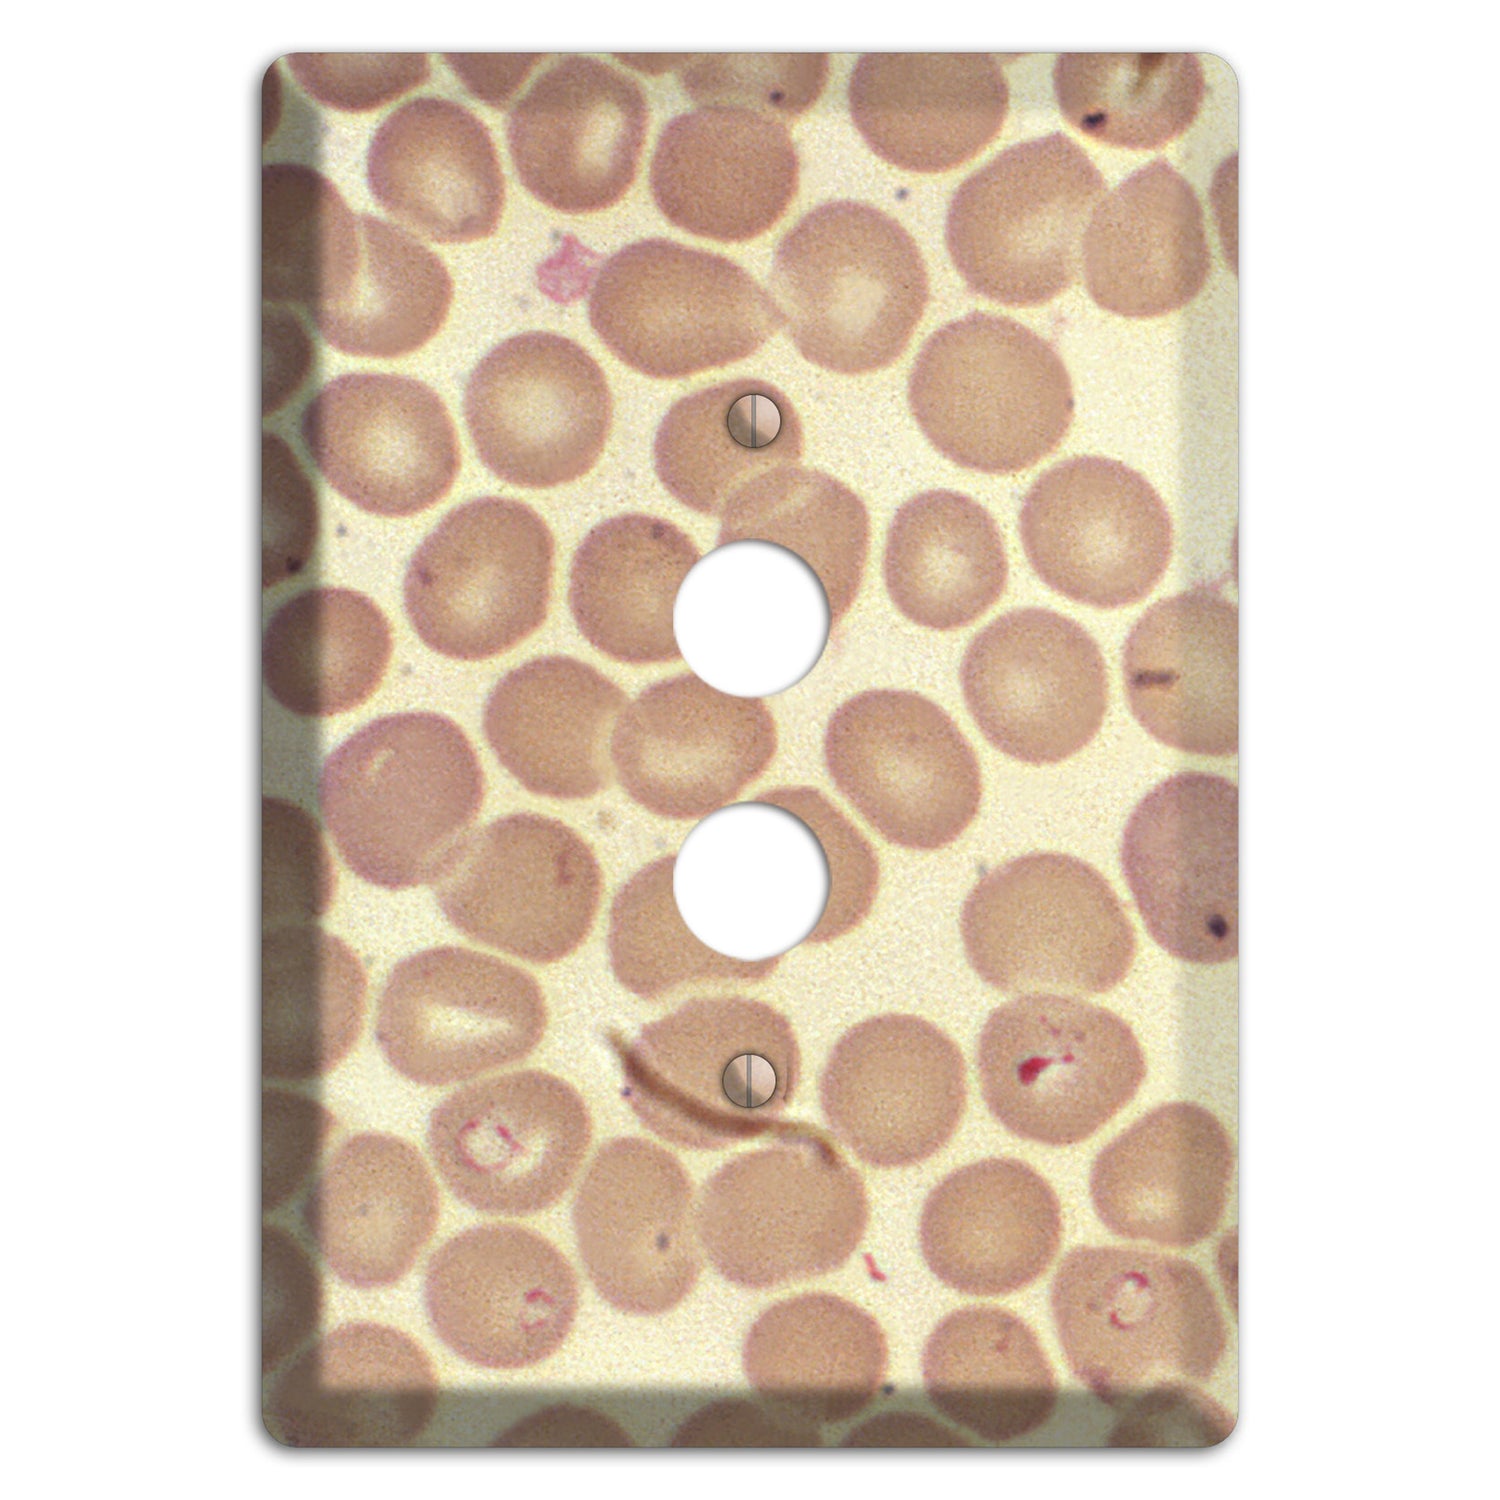

Babiesa 1 Pushbutton Wallplate
The Babiesa 1 Pushbutton Wallplate are very unique and cannot be found anywhere else. These USA made metal plates are highly detailed and made with some of the newest UV imaging technology available resulting in photograph quality prints on durable metal switchplates.
Specifications
Specifications
Material: UV Printed Metal
Country of Manufacturer: USA
Shipping Time: Ships in 1-3 business days
Screws: Matching Screws included
Size 1: 3.5 x 5 in
Size 2: 4.5 x 5 in
Size 3: 6.375 x 5 in
Size 4: 8.18 x 5 in
Size 5:
Sizes refer to amount of gangs in plate:
Size 1 is for single toggles, single rockers, etc.
Size 2 is for double toggles, double rockers, etc.
Size 3 is for 3 toggles, 3 rockers, etc.
Reviews
Reviews
Policies
Policies
 Proudly made in USA
Proudly made in USA

choose configurations below
Couldn't load pickup availability